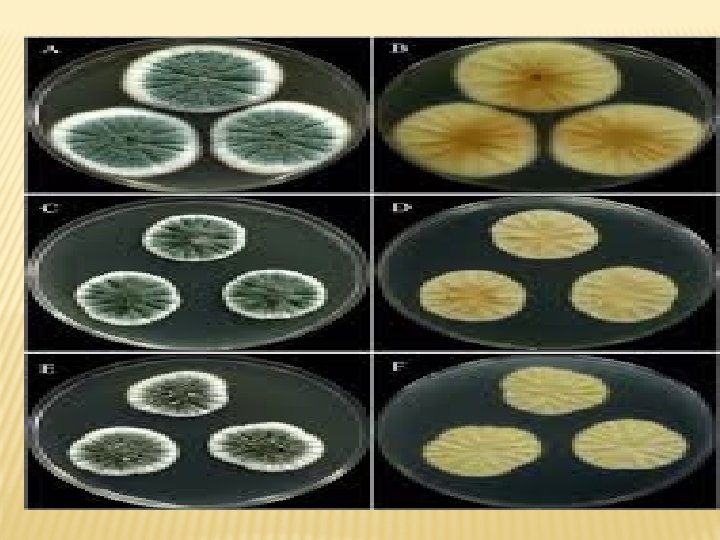

Opportunistic infection Assistant professor Hams M A Mohamed


![� � � � Species] Selected species include; F. avenaceum F. bubigeum F. culmorum � � � � Species] Selected species include; F. avenaceum F. bubigeum F. culmorum](https://slidetodoc.com/presentation_image_h2/f336a5de9c586cbd0571ab519c18284e/image-3.jpg)
















- Slides: 19

Opportunistic infection Assistant professor. Hams M. A. Mohamed

FUSARIUM Fusarium is a large genus of filamentous fungi, up to 1, 000 species , apart of a group often referred to as hyphomycetes, widely distributed in soil and associated with plants. Most species are harmless and are relatively abundant members of the soil microbial community. Some species produce mycotoxins in cereal crops that can affect human and animal health if they enter the food chain. The main toxins produced by these Fusarium species are fumonisins and trichothecenes, Zearalenon �
![Species Selected species include F avenaceum F bubigeum F culmorum � � � � Species] Selected species include; F. avenaceum F. bubigeum F. culmorum](https://slidetodoc.com/presentation_image_h2/f336a5de9c586cbd0571ab519c18284e/image-3.jpg)
� � � � Species] Selected species include; F. avenaceum F. bubigeum F. culmorum F. graminearum F. langsethiae F. oxysporum F. poae F. sporotrichioides F. tricinctum F. verticillioides F. virguliforme

PATHOGENESIS some species may cause a range of opportunistic infections in humans. In humans with normal immune systems, fusarial infections may occur in the nails and in the cornea , In humans whose immune systems are weakened in a particular way, (neutropenia, i. e. , very low neutrophils count), aggressive fusarial infections penetrating the entire body and bloodstream (disseminated infections) may be caused by members of the Fusarium solani complex, Fusarium oxysporum, Fusarium verticillioides, Fusarium proliferatum

DISEASES � Zearalenon: in different animals � Oestrogenic syndrom � Vulvovaginits , emetic syndrom � Trichthescenes: in poultry � White cream colored ulcers in border of mouth in poultry � CNS manifestation � Haemorhagic syndrom

DIAGNOSIS � Direct microscopic examination � Film stained lactophenol methylen blue � Cresentric shape macroconidia � chylamydospores

CULTURE � Sabourauds dextrose agar � Cotton, pink purple to deep rose � Color, reverse white color � Mycotoxin detection: � By TLC, HPLC

ASPERGILLUS SPP. Aspergillus spp. are widely distributed fungal moulds found in soil and other organic matter. They have also been isolated in air-conditioning systems. There are more than a hundred different species but most human disease is caused by Aspergillus fumigatus or Aspergillus niger. Occasionally, Aspergillus clavatus and Aspergillus flavus cause human illness.

ASPERGILLUS FUMIGATUS Microscopic appearance: Staining lactophenol blue conidiophore hyaline, 200 − 325µ Long and 3 − 5µ wide, vesicle ovate to flask shape 15 − 20µ in diameter, sterigmata uniseriates, phialides ampuliform,

CULTURE � Sabourauds dextrose agar � Colony color blue grey colony, reverse hyaline

MYCOTOXINS DISORDERS � Aflatoxicosis: � A. flavus: Aflatoxin B 1, B 2, G 1, G 2 � Ochratoxicosis: � A. niger and A. ochraceus: ochratoxin � Detection by HPLC, TLC

DISEASES � IN POULTRY � Brooder pneumonia(green hyphae lining air sac, granulmatous nodules in lung �In cattle � Mycotic abortion � Fungal growth between cotlydons � With mycotic pneumonia � Granuloma in mammary glands

Penicellium Economic value � � everal species of the genus Penicillium play a central role in the production of cheese and of various meat products. To be specific, Penicillium molds are found in Blue cheese. Penicillium camemberti and Penicillium roqueforti are the molds on Camembert, Brie, Roquefort, and many other cheeses. Penicillium nalgiovense is used to improve the taste of sausages and hams, and to prevent colonization by other molds and bacteria The genus includes a wide variety of species molds that are the source molds of major antibiotics. Penicillin, a drug produced by. P. chrysogenum (formerly P. notatum), was accidentally discovered by Alexander Fleming in 1929, and found to inhibit the growth of Grampositive bacteria

PENICILLIUM MYCOTOXINS � Some Penicillium species cause damage by secretion of mycotoxin � Ochratoxin by Penicillium viridictum � Rubratoxin by Penicillium rubrum � Rubroskyrin by Penicillium spp. � Rubrosulphinby Penicillium viridicatum � Rugulosin by. Penicillium brunneum, P. kloeckeri, rugulosum �

Microscopic ex: � species of Penicillium are recognized by their dense brush-like spore-bearing structures called penicilli (sing. : penicillus). The conidiophores are simple or branched and are terminated by clusters of flask-shaped phialides. The spores (conidia) are produced in dry chains from the tips of the phialides, with the youngest spore at the base of the chain, and are nearly always green. Branching is an important feature for identifying Penicillium species.

Some, such as Penicillium glabrum at left, are unbranched and simply bear a cluster of phialides at the top of the stipe. Others (middle photo) may have a cluster of branches, each bearing a cluster of phialides. Penicillum atramentosum, at right, represents a third type haing branches that bear a second order of branches, bearing in turn a cluster of phialides. These three types of spore bearing systems (penicilli) are called monoverticillate, biverticillate and terverticillate respectively. Penicillium is a large and difficult genus encountered almost everywhere, and usually the most abundant genus of fungi in soils.

PENICELLIUM

CULTURE � Colonies are usually � fast growing, � in shades of green, � sometimes whit